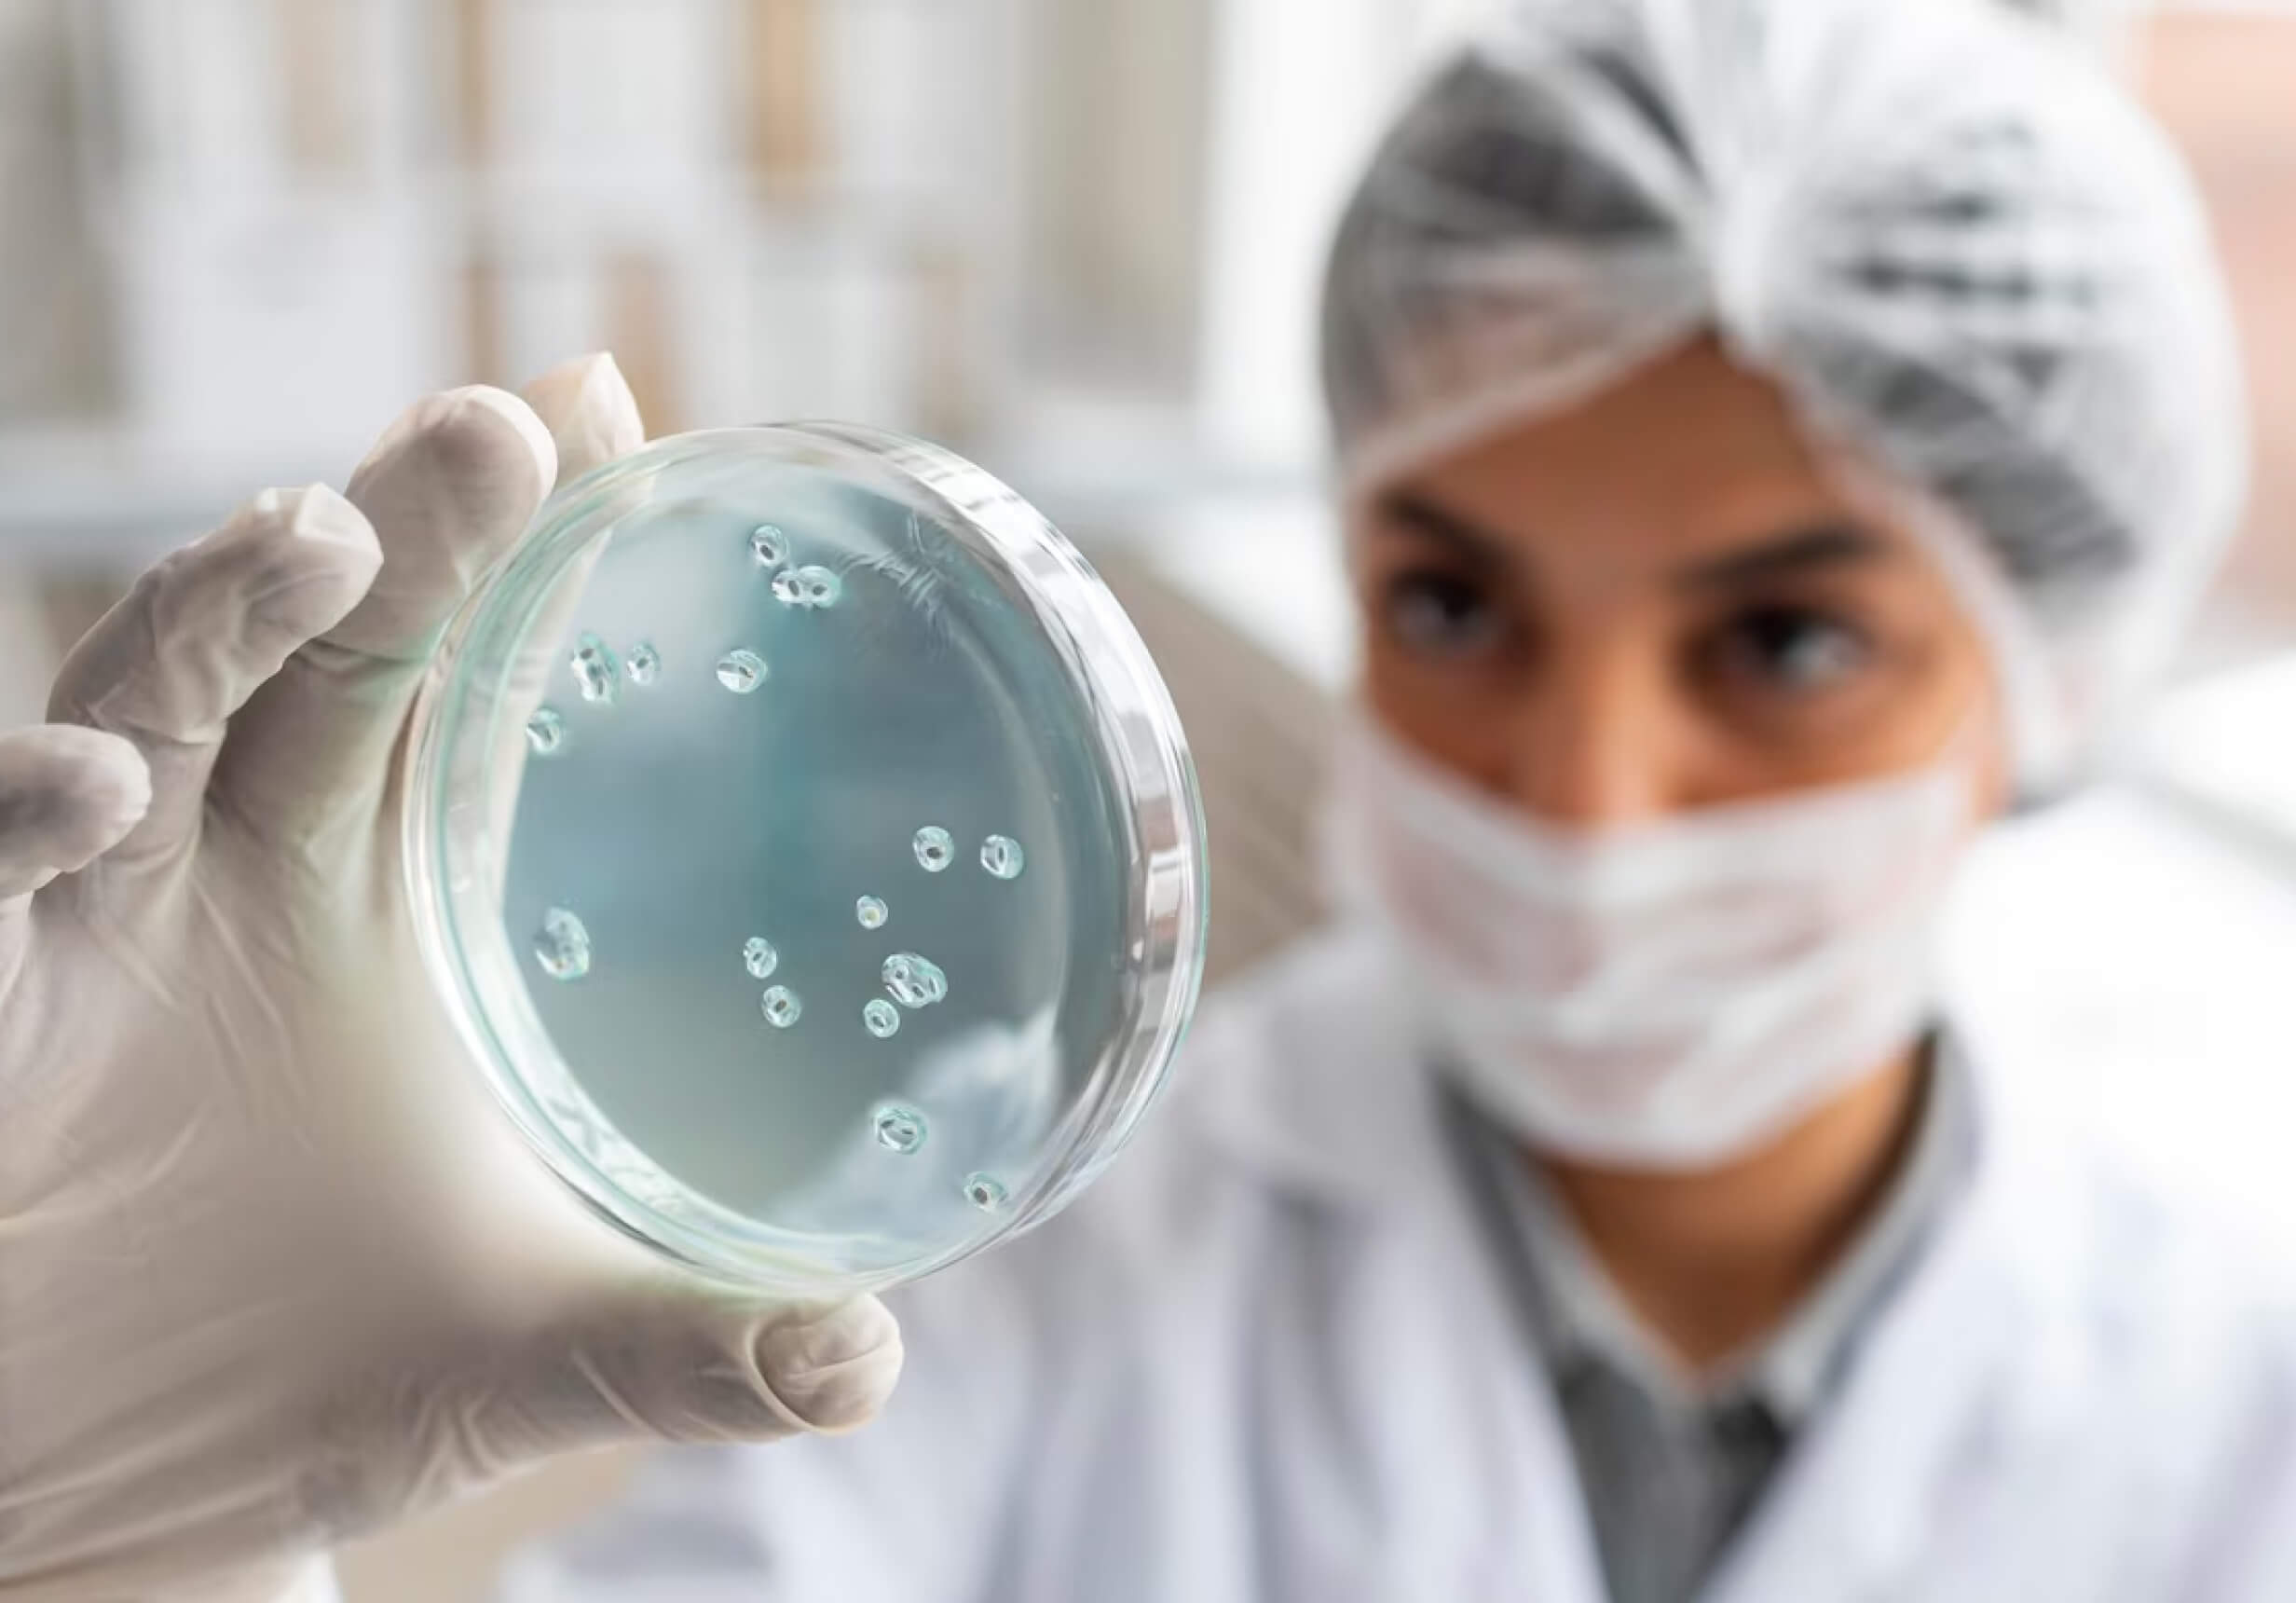
image

инновации
Магнитные микроботы против опасных бактерий в молоке
MagRobots — это небольшие микророботы, которые можно использовать для очистки молока и молочных продуктов путем извлечения опасных бактерий, таких как клетки золотистого стафилококка. Система использует магнитные поля, чтобы привлекать и затем убивать вредные клетки, оставляя безвредные бактерии невредимыми. Это означает, что MagRobots не причиняют вреда людям или другим животным (что не может быть подтверждено магнетизмом). Он также не токсичен для людей, не оставляет следов в пище и не требует дорогостоящего оборудования для постоянного использования.
Стафилококковые бактерии являются основной причиной мастита и септицемии у крупного рогатого скота. Воспаление молочной железы (мастит) у крупного рогатого скота часто связано с заражением бактериями Staphylococcus aureus - золотистый стафилококк. От животных микробы попадают в молоко и кисломолочные продукты и могут привести к развитию у человека целого комплекса заболеваний – от легких форм акне на коже до крайне опасных поражений нервной системы и оболочек сердца. Особую озабоченность вызывает отличная способность этих бактерий вырабатывать устойчивость к антибиотикам.
MagRobots снижают содержание стафилококков до показателей, которые считаются полностью безопасными. При этом они высокоспецифичны и не действуют на другие виды бактерий, в том числе на молочнокислые, которые могут содержаться в некоторых продуктах. По словам разработчиков, этот метод удобен еще и тем, что не требует затрат энергии, добавления дополнительных химикатов и легко масштабируется для промышленного использования.

